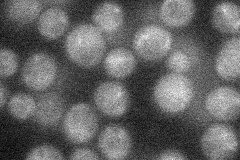
YJR120W
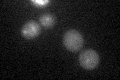
YJR120W

View description
Protein of unknown function; essential for growth under anaerobic conditions; mutation causes decreased expression of ATP2, impaired respiration, defective sterol uptake, and altered levels/localization of ABC transporters Aus1p and Pdr11p
Localization:
Intensity:
Fold change:
Significance:
-
C’ GFP library in SD

below threshold19.23 -
N' NOP1pr-GFP in SD
below threshold20.9648 -
N' TEF2pr-mCherry in SD

ambiguous4.64875 -
N' NATIVEpr-GFP in SD

below threshold19 -
N' TEF2pr-VC and Cyto-VN in SD

#N/A0 -
C’ GFP library in SD+DTT
cytosol15.520.8No -
C’ GFP library in SD+H2O2

cytosol18.860.98No -
C’ GFP library in Starvation Media

cytosol17.230.89No -
C’ GFP library on the background of Pup2-DaMP

below threshold -
C’ GFP library on the background of CCT mutant

below threshold15.89460.826331No
